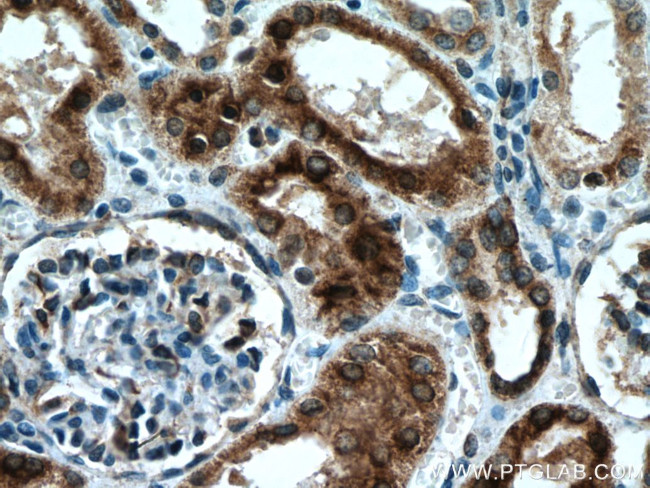
nNOS Antibody in Immunohistochemistry (Paraffin) (IHC (P))
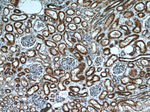
nNOS Antibody in Immunohistochemistry (Paraffin) (IHC (P))

Search
Proteintech
nNOS Polyclonal Antibody
{{$productOrderCtrl.translations['antibody.pdp.commerceCard.promotion.promotions']}}
{{$productOrderCtrl.translations['antibody.pdp.commerceCard.promotion.viewpromo']}}
{{$productOrderCtrl.translations['antibody.pdp.commerceCard.promotion.promocode']}}: {{promo.promoCode}} {{promo.promoTitle}} {{promo.promoDescription}}. {{$productOrderCtrl.translations['antibody.pdp.commerceCard.promotion.learnmore']}}
产品信息
18984-1-AP
种属反应
宿主/亚型
分类
类型
抗原
偶联物
形式
浓度
规格
纯化类型
保存液
内含物
保存条件
运输条件
产品详细信息
The antibody can recognize isoforms 1, 2, and 4 of NOS1.
靶标信息
NOS activity requires homodimerization as well as three cosubstrates (L-arginine, NADPH and O2) and five cofactors or prosthetic groups (FAD, FMN, calmodulin, tetrahydrobiopterin and heme). Several distinct NOS isoforms have been described and been shown to represent the products of three distinct genes. These include two constitutive Ca2+/CaM-dependent forms of NOS, including NOS1 (also designated ncNOS) whose activity was first identified in neurons, and NOS3 (also designated ecNOS), first identified in endothelial cells.
仅用于科研。不用于诊断过程。未经明确授权不得转售。
生物信息学
蛋白别名: bNOS; bNOS1; Brain NOS; Constitutive NOS; N-NOS; NC-NOS; Neuronal NOS; nitric oxidase synthase; Nitric oxide synthase 1; nitric oxide synthase 1 (neuronal); Nitric oxide synthase, brain; nNOS; NOS Type 1; NOS type I; Peptidyl-cysteine S-nitrosylase NOS1; Phospho-bNOS; Phospho-Brain NOS; unnamed protein product
基因别名: 2310005C01Rik; Bnos; IHPS1; N-NOS; NC-NOS; nNOS; NO; NOS; Nos-1; NOS-I; NOS1
UniProt ID: (Human) P29475, (Rat) P29476, (Mouse) Q9Z0J4
Entrez Gene ID: (Human) 4842, (Rat) 24598, (Mouse) 18125